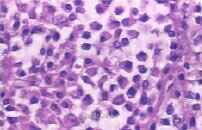

患者男,63岁。无明显诱因出现左侧睾丸胀痛伴排尿疼痛不适,病情反复发作1个月余,抗炎对症治疗后无明显好转。
查体:左阴囊触及6 cm×5 cm×4 cm肿块,质硬、表面欠光滑,触痛明显;右阴囊未及明显肿块,睾丸及附睾无触痛。MRI检查:双侧睾丸肿块在T:WI+Fs序列上呈略等低信号,边缘光整,T。WI序列上呈略等高信号,增强后双侧睾丸肿块明显均匀强化。腹部CT VR提示T1 2、L1、L2及左侧髂骨多处虫蛀状骨质破坏,且左侧髂骨破坏区伴发软组织肿块。影像诊断:双侧睾丸恶性肿瘤伴脊柱、髂骨转移。
全麻下行双侧睾丸肿瘤根治性切除术。病理巨检:左侧睾丸大小6.0cm x5.5 cm x3.5 cm,切面见睾丸实性、质软,被肿瘤浸润,质中;右侧睾丸大小约5.0 cm x3.5 cm×3.0 cm,切面见一灰白肿块,直径1.6 cm,境界清。镜检:肿瘤细胞弥漫成片分布,部分有小的纤维间隔,细胞胞质丰富,核偏位,细胞异型明显;免疫组化示:瘤细胞CD79a(+)、CDl38(+)、骨髓瘤原癌基因l(MUM-1)(+)、碱性磷酸酶(PLAP)(+)、K灶(+)、Ki-67瘤细胞阳性率约为20%、CD3(一)、CD20(一)、CD56(一)、CDll7(一)、Ot.Inhibin(一)。病理诊断:“双侧睾丸”浆细胞瘤,附睾及精索切缘未见肿瘤累及。

浆细胞瘤是一种异常的浆细胞增殖,产生单克隆免疫球蛋白的血液病。浆细胞瘤可分为多发性骨髓瘤和孤立性浆细胞瘤口。孤立性睾丸浆细胞瘤十分罕见,可为多发性骨髓瘤侵至睾丸或髓外浆细胞瘤原发于睾丸。亦有浆细胞白血病进展为睾丸浆细胞瘤的报道。多数睾丸浆细胞瘤以无痛性睾丸肿块为首发表现,可有或没有触痛,骨髓瘤累及睾丸者可有典型的临床表现,如骨痛、贫血及出血倾向、感染、肾脏损害等。睾丸浆细胞瘤大多为超声检查方面的报道。睾丸浆细胞瘤可被误诊为其他类型的肿瘤,但其影像学表现还是有一定的区别;如精原细胞瘤通常表现为一侧睾丸边缘光滑的均质性肿块,增强后轻度强化为其主要特征;畸胎瘤可见钙化、脂肪等成分,文献报道50%的混合型生殖细胞瘤包含畸胎瘤成分H1;非精原生殖细胞瘤的MRI特点为信号不均匀,多见出血、坏死,增强后轻到中度不均匀强化∞J。睾丸浆细胞瘤术前诊断较困难,询问既往病史尤为重要,对于有淋巴瘤、骨髓瘤病史者,发现睾丸肿块,应考虑睾丸浆细胞瘤的可能。为明确诊断,可进行CD 138、CD 79a与单克隆抗体VS 38免疫染色。无论何种睾丸浆细胞瘤,治疗上首先行根治性患侧睾丸切除术。骨髓瘤累及睾丸者术后需行化疗,常用美法仑加泼尼松的MP方案。此外,这些肿瘤对放射线高度敏感,可行手术与放疗联合治疗。睾丸浆细胞瘤患者的总体预后差,进展至多发性骨髓瘤的比率高,因此需长期密切随访观察。